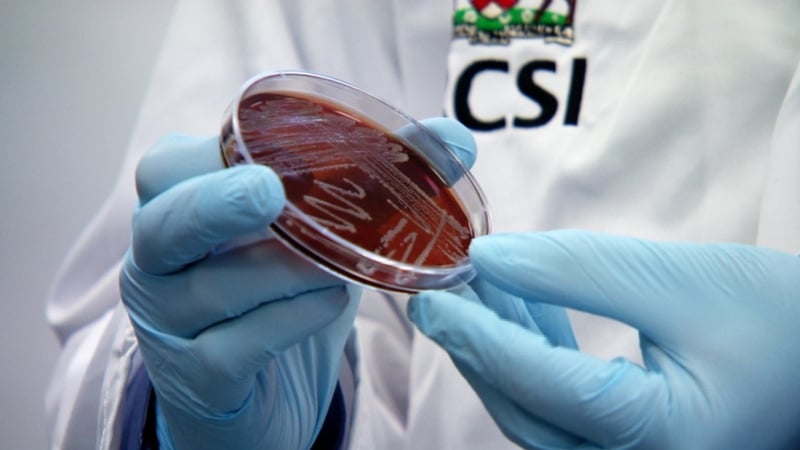
Sepsis claims more lives in Ireland than heart attack, breast cancer or lung cancer

An Irish couple living in New York will receive the presidential award from President Michael D Higgins next month at Áras an Uachtaráin, in recognition of their work in raising awareness about sepsis.
Ciarán and Orlaith Staunton established End Sepsis: The Legacy of Rory Staunton, following the death of their 12-year-old son Rory from the condition on 1 April 2012.
Sepsis is an abnormal life-threatening response to infection. When bacteria gain access to the bloodstream, white blood cells can react by releasing damaging chemicals to try to control the infection.
This white blood cell response can cause damaging inflammation which can lead to septic shock, organ failure and death.
Orlaith Staunton, who is originally from Drogheda in Co Louth, and her husband Ciarán, originally from Louisburgh in Co Mayo, lived in Queens with Rory and his sister Kathleen.
Mr Staunton said Rory was "a fine young man, he was five foot nine when he died, he was 11 stone".
Speaking on RTÉ's Sunday with Miriam, Mr Staunton said his son "very interested in life, he had lots of questions on international politics, science and technology and he captained the school team debate".
He added: It's shocking that on one Tuesday evening, I brought this young man out for pizza and the question was 'what type of pizza do you want?' and a week later we were in a funeral home where they were asking me 'what kind of coffin do you want?'"
Mrs Staunton explained the events leading up to Rory's tragic death.
"He came home and he two plasters on his elbow and he said that he had been playing basketball in the school and he had fallen and the gym teacher had put the plasters on his arm.
"What we know is he did fall and they didn't wash the wound," she said.
She said Rory's condition began to deteriorate overnight.
"He did some homework, ate some pizza and then just a little after midnight we heard him up and he was throwing up.
"I went into him and he was saying 'it's my leg mom, my leg'.
"The next morning he had a very high fever of 104 and no matter what I gave him the fever wouldn't go."
After visiting his paediatrician and a hospital emergency department, Rory was discharged with a prescription for flu. However, his condition did not improve and he returned to the ER the following evening with his parents.
"It was just like a scene from [the TV series] ER, they came running from everywhere and they brought him immediately to the ICU, they told us he was very ill and he had an infection.
"Rory died on the Sunday evening and that was it, our lives just changed forever."
Following Rory's death, his parents began to raise awareness.
"When Rory died, 70% of American's hadn't heard about it [sepsis} and even when we launched a number of sepsis initiatives in Ireland with the then minister for health, we had the same thing. People had not heard about sepsis, were not aware of it," Mr Staunton said.
"One of the things we have done here is that when medical professionals are renewing their licence, under Rory Staunton's Law...they have to have to train in sepsis," Mr Staunton said.
"Right now 350,000 Americans die from sepsis every year," Mrs Staunton said.
Mr Staunton said both he and his wife are "deeply honoured" to be receiving an award from President Higgins on 8 December.
"We are deeply honoured to accept this presidential award in memory of our son and in recognition of our family's life saving work...it's Rory's legacy, the thing to remember is that Rory should not have died. We have created an international movement.
"We are not waiting for a cure for sepsis, we know the cure, what we are waiting for is leadership, leadership is what's costing us here."